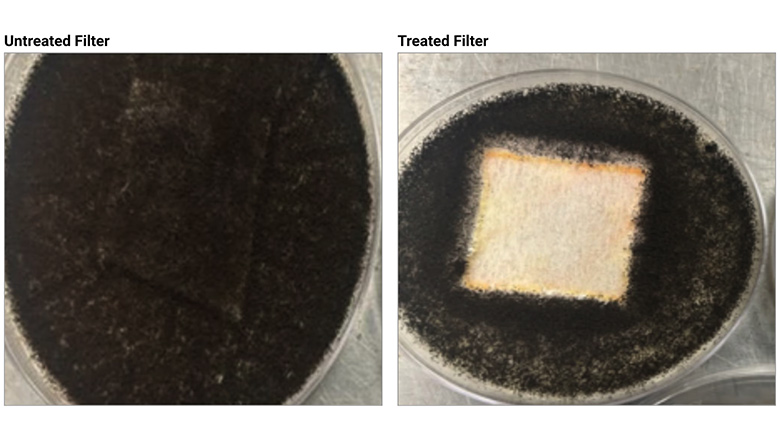
Untreated filter (left) supports fungal growth versus treated filter (right), which shows significantly less growth.

The Science of Modern Coatings
Bridging Formulation and Functionality

From a water-repellent finish on an awning to the durable topcoat on hardwood floors, industrial coatings are integral to a product’s performance and longevity. However, the expectations of coating technologies are rapidly evolving. Today’s market demands more than just passive protection; it requires multifunctional solutions that address complex challenges. This shift is driving a new era in coatings development, moving away from single-purpose formulations toward modular, platform-based systems that can be tailored to meet a wide array of technical and functional requirements.
Evolving Demands and Challenges
Traditional coatings are often optimized around key physical properties such as scratch resistance or UV durability. While effective, these systems leave gaps in applications where multiple stresses — mechanical, environmental and biological — occur simultaneously to reduce performance. Formulators are now expected to combine resistance to abrasion, moisture and/or UV light with additional attributes such as antimicrobial performance, easy-clean functionality or odor control, for example.
This evolution presents challenges for formulators and manufacturers. The complexity of modern coating makes it difficult to communicate their full value to end users, who often do not have the technical expertise to understand the nuances of properties such as mar resistance or anti-blocking. At the same time, the industry is under pressure to accelerate product development cycles and improve efficiency, requiring a more streamlined approach to formulation and manufacturing.
Platform-Based Approaches to Multifunctional Coatings
To address these complexities, coating developers are increasingly adopting modular platforms that allow properties to be combined without extensive reformulation. Such systems rely on creative integration of advanced polymer chemistries, surface engineering and additive technologies. Through in-depth formulation, these platforms allow antimicrobial agents, surface energy modifiers, odor control additives and other additives such as UV stabilizers to function together without diminishing the coating’s aesthetics and primary role.
This new approach has led to the development of AkoTech,™ which is built on a foundation of advanced polymer chemistry and surface engineering by Microban International. Rather than functioning as a single product, it serves as a library of formulations and functional additives that can be adjusted for different substrates or applications. The platform’s core strength lies in its ability to combine customizable surface protection features such as scratch resistance, hydrophobicity or UV stability with antimicrobial, odor control and other supplemental technologies that expand the coating’s capabilities.
For instance, an exterior topcoat may offer excellent UV resistance, but the addition of antimicrobial agents at the polymer level provides an additional layer of product protection. These technologies are engineered to be PFAS free, heavy-metal free and durable, ensuring long-term efficacy without compromising the coating’s physical properties. The platform’s modularity allows formulators to select from a library of formulations and technical additives, enabling rapid customization for diverse applications. Whether the goal is to create an easy-to-clean surface for kitchen appliances or a mildew-resistant coating for outdoor furniture, the platform provides a pre-engineered framework that saves time and resources.
By leveraging sophisticated polymer science, the platform can be adapted to various substrates including plastics, metals, wood and concrete. The formulations are engineered to achieve superior adhesion, flexibility and durability, ensuring a long lifespan. The seamless integration of these properties is a direct result of meticulous research and development, which focuses on ease of use and compatibility to prevent any compromise in performance.
Streamlining Formulation and Manufacturing
Platform strategies also influence manufacturing. By offering starting point formulas, ready-to-use or concentrates, developers can provide coatings that are compatible with existing application methods — spraying, roll-to-roll or dip coating — while reducing time spent on in-house mixing and dispersion.
Starting Point Formulations
These are pre-optimized, scientifically validated baselines that formulators can use as a foundation for their specific projects. They are engineered to work with different substrates and application methods, significantly reducing the R&D time typically required for a new coating’s development. Instead of building a formulation from scratch, formulators can start with a robust, proven system and make minor adjustments for specific performance or aesthetic requirements, such as adding custom colorants or texture agents.
Ready-to-Use Coatings and Concentrates
For manufacturers, coatings platforms can provide flexible delivery formats that seamlessly integrate into existing production lines. Ready-to-use options eliminate the need for in-house weighing, mixing and dispersion, making them ideal for lean manufacturing environments. In contrast, concentrate formulations offer scalability and logistical efficiency, particularly for large-scale or global operations where localized dilution and blending are more cost-effective. Even better, a dual approach ensures that, regardless of a facility’s size or complexity, the technology can be adopted with minimal disruption.
Operational efficiency is critical in today’s fast-paced market. It allows manufacturers to respond to new trends and consumer demands more quickly while also reducing waste and the high costs associated with extensive trial-and-error cycles. The platform approach reflects a broader industry trend: integrating efficiency with functionality across the entire value chain.
Technical Performance in Practice
To demonstrate the efficacy of multifunctional coatings platforms, let’s examine a few examples, each representing a different formulation from the AkoTech platform. The following data highlights the technical performance of these coatings across various applications.
Starting Point Formula Example: CTR-1001
CTR-1001 is a durable, water-based clear coat engineered for a variety of substrates, including concrete, wood and plastics. Its performance is characterized by exceptional physical durability and chemical resistance.
¹ Taber Abrasion (ASTM D4060-90): CS-17 wheels, 1000 g weight
In addition to its physical properties, this formulation demonstrates significant antimicrobial performance, a key technical feature of the platform.
Ready-to-Use Coating Example: CTR-1002
CTR-1002 is a clear, PFAS-free omniphobic coating. Its primary technical function is to provide an easy-to-clean surface by repelling both water and oil. This is achieved through unique surface tension engineering that prevents streaking and residue accumulation on glass, cementitious, ceramic and metal substrates. This technology also provides up to a 99.99% reduction in bacteria and fungi.

This formulation illustrates how the platform can be used to develop highly specialized coatings with specific functionalities.
Concentrate Formulation Example: CTR-1003
CTR-1003 is a highly versatile concentrate designed to create a durable, waterproof and antimicrobial barrier. Its flexibility and long-lasting properties make it suitable for a wide range of cellulosic and synthetic fibers, particularly in filtration media and nonwovens. The following data highlights the technology’s ability to inhibit microbial growth, which is critical for preventing material degradation and odor in HVAC systems and other industrial applications.
These results display a platform’s technical versatility and effectiveness across different applications.
A New Paradigm for Coating Innovation
Multifunctional coatings platforms empower formulators to innovate more efficiently, reduce the barriers for manufacturers to adopt new technologies and ultimately deliver coatings that provide superior, demonstrable functionality.
By bridging formulation science with functional performance, coatings evolve from passive layers into active, multifunctional product components. As the industry continues to ask for more from coating technologies, the ability to rapidly develop, test and scale these advanced coating systems will be a key differentiator for success.
Learn more about advancements in industrial coatings through PCI’s dedicated resource hub on the topic.
Looking for a reprint of this article?
From high-res PDFs to custom plaques, order your copy today!







